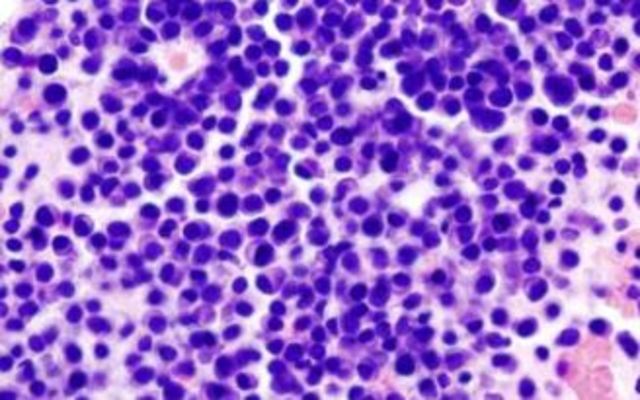
La terapia génica se incorpora al arsenal contra el cáncer

-
Leucipo de Mileto y Demócrito fueron los defensores más célebres del preformacionismo. Es una antigua teoría biológica según la cual el desarrollo de un embrión no es más que el crecimiento de un organismo que estaba ya preformado (homúnculo). Proponía que el organismo tenía todas sus partes previamente formadas. Bibliografía:
http://conceptos.sociales.unam.mx/conceptos_final/428trabajo.pdf
https://estudosmarxistas.files.wordpress.com/2011/06/iovchuk-historia-de-la-filosofc3ada-t1-completo.pdf -
Leucipo de Mileto y Demócrito fueron los defensores más célebres del preformacionismo. Es una antigua teoría biológica según la cual el desarrollo de un embrión no es más que el crecimiento de un organismo que estaba ya preformado (homúnculo). Bibliografía:
http://conceptos.sociales.unam.mx/conceptos_final/428trabajo.pdf
https://estudosmarxistas.files.wordpress.com/2011/06/iovchuk-historia-de-la-filosofc3ada-t1-completo.pdf -
-
Hipócrates, planteó una teoría que explica el parecido de los padres con los hijos, la supuesta herencia de caracteres adquiridos. Cada parte del cuerpo produce algo por las células germinales. Esta teoría recibió posteriores aportaciones de científicos hasta ser refutada con los nuevos avances en la ciencia. Bibliografía:
http://www.medigraphic.com/pdfs/facmed/un-2004/un044j.pdf
http://www.unioviedo.es/esr/pp/una_historia_de_la_genetica.pdf -
pigenética. Aristóteles (384-322 ac), propone la epigenética del desarrollo de la forma orgánica del individuo a partir de materia amorfa, la cual se desarrollaba dentro de la madre, gracias al padre. Bibliografía: http://epigenome.eu/es/1,1,0
-
Aristóteles (384-322 ac), propone la epigenética del desarrollo de la forma orgánica del individuo a partir de materia amorfa, la cual se desarrollaba dentro de la madre, gracias al padre. Bibliografía: http://epigenome.eu/es/1,1,0
-
William Harvey (1578-1657), realizó experimentos en embriones de pollo (basándose en lo expuesto por Aristóteles) y llegó a convencerse de que los embriones se desarrollan de forma gradual a partir de un óvulo y no a partir de cuerpos minúsculos completamente formados. Bibliografía; http://epigenome.eu/es/1,22,596
-
Robert Hooke (1635-1703), publicó los resultados de sus observaciones sobre tejidos vegetales, como el corcho. Fue el primero en ver que esos tejidos presentaban unidades que se repetían a modo de celdillas de un panal, por ende, las bautizo como elementos de repetición, «células» (del latín cellulae, celdillas). Sin embargo solo observo células muertas. Bibiografía: https://normaconstanzab.wordpress.com/historia-y-teoria-celular/
-
Anton van Leeuwenhoek (1632-1723), observó diversas células eucariotas (como protozoos y espermatozoides) y procariotas (bacterias). Bibliografía: http://historiaybiografias.com/leeuwenhoek/
-
Theodor Schwann y Matthias Schleiden, postularon que las células son las unidades elementales en la formación de las plantas y animales, y que son la base fundamental del proceso vital. Dando origen a la teoría celular. Bibliografía: http://www.asturnatura.com/articulos/estructura-funcion-celular/teoria-celular.php
-
Robert Brown (1773-1857), dio nombre a una estructura común en todas las células eucariotas, a dicha estructura denomino "núcleo celular". Bibliografía: https://normaconstanzab.wordpress.com/historia-y-teoria-celular/
-
Karl Wilhelm von Nägeli (1817 - 1891), descubrió la existencia de los cromosomas. Bibliografía: http://cmcbemartineznderqui.jimdo.com/un-poco-de-historia/
-
Rudolf Virchow (1821-1902), postuló que todas las células provienen de otras células. Bibliografía: https://normaconstanzab.wordpress.com/historia-y-teoria-celular/
-
Charles Darwin publicó el libro “El Origen de las especies por medio de la selección natural, o la preservación de las razas preferidas en la lucha por la vida”. Bibliografía: http://genesis.uag.mx/edmedia/material/vidayev/Tema04.cfm
-
Gregor Mendel (1822-1884), a partir de experimentos realizados con gisantes, elaboró las reglas o leyes de la herencia, que son la base de la genética actual. Bibliografía: http://www.unioviedo.es/esr/pp/una_historia_de_la_genetica.pdf
-
Johan Friedrich Miescher (1844 - 1895), aisló la molécula de la vida 75 años antes de que Watson y Crick revelaran su estructura. Denomino nucleicos a un nuevo grupo de sustancias localizadas en el núcleo celular. Bibliografía: http://biologiabiomolecular.blogspot.com/2013/07/historia-y-descubrimiento-del-adn.html
http://cmcbemartineznderqui.jimdo.com/un-poco-de-historia/ -
Ludwig Karl Martin Leonhard Albrecht Kossel (1853 - 1927), abrió paso a la investigación sobre la constitución química del núcleo de la célula. Descubrió que las nucleoproteínas contienen una parte proteica y no proteica. halló las bases heterocíclicas nitrogenadas de la adenina y la timina. Bibliografía: http://cmcbemartineznderqui.jimdo.com/un-poco-de-historia/
-
Walther Flemming (1843-1905), aplicó colorantes derivados de la anilina y pudo observar al microscopio la existencia de estructuras en forma de cintas que absorbían fuertemente el colorante en el núcleo, a las que denominó "cromatina". Bibliografía: http://cmcbemartineznderqui.jimdo.com/un-poco-de-historia/
-
Walther Flemming (1843-1905) Observó quedurante la mitosis celular estas cintas (cromatina) se dividían longitudinalmente en dos mitades idénticas. Se ofrecía el primer resultado experimental que acusaba la existencia de estructuras en el núcleo que se detectaban y se segregaban en pares a las células hijas durante la división celular. Bibliografía: http://cmcbemartineznderqui.jimdo.com/un-poco-de-historia/
-
Richard Altmann (1852 – 1900), identificó a las nucleina como sustancias ácidas y las denomino con el nombre de "ácidos nucleicos". Esta sustancia se encontró que sólo existen en los cromosomas. Bibliografía: http://biologiabiomolecular.blogspot.com/2013/07/historia-y-descubrimiento-del-adn.html
http://cmcbemartineznderqui.jimdo.com/un-poco-de-historia/ -
Paul Ehrlich, fue el primer uso del término "anticuerpo" se produjo en un texto donde el término "Antikörper"(la palabra alemana para anticuerpos) aparece en la conclusión de su artículo "Los estudios experimentales sobre la inmunidad" Bibliografía: http://www.ecured.cu/Anticuerpo
-
August Weissmann (1834-1914) y otros. Reconocieron que la información genética era almacenada en el núcleo de la célula, considerado la pérdida de información en la división celular. Bibliografía: http://epigenome.eu/es/1,22,598
-
Phoebus Levene (1869-1940), comprobó que la nucleina se encontraba en todos los tipos de células animales analizadas. Bibliografía: http://cmcbemartineznderqui.jimdo.com/un-poco-de-historia/
-
Hugo de Vries, Eric Von Tschermak y Karl Erich Correns, redescubren de forma simultanea las leyes de Mendel. Bibliografía: http://www.mas-que-ciencia.com/redescubrimiento-mendel/
-
Hans Spemann (1869-1941), argumentó que las células no pierden información; simplemente la desactivan. Usó un pelo de su bebé para dividir en dos un huevo de salamandra. Obtuvo dos salamandras.
Spemann fue el pionero de la moderna tecnología utilizada hoy día para la clonación Bibliografía: http://epigenome.eu/es/1,22,599 -
Theodor Boveri (1862-1915) y Walter Sutton (1877-1916), observaron que había un paralelismo entre la herencia de los factores hereditarios y el comportamiento de los cromosomas durante la meiosis y la fecundación, por lo que dedujeron que los factores hereditarios residían en los cromosomas. Biblografía: http://mendel.ugr.es/~rnavajas/docs/TEMA_2_GI.pdf
http://marcoasv281.blogspot.com/2012/10/trabajos-de-sutton-y-theodor-boveri.html -
Phoebus Levene (1869-1940), puso de manifiesto que los ácidos nucleicos estaban compuestos de ácido fosfórico, una pentosa y las bases nitrogenadas. Bibliografía: http://cmcbemartineznderqui.jimdo.com/un-poco-de-historia/
-
Thomas Hunt Morgan (1866-1945), descubrió la relación entre los caracteres hereditarios y el sexo. Bibliografía: http://es.calameo.com/read/00186856327614b8bc0f8
-
Wilhelm Ludvig Johannsen (1857 - 1927) realizó una sobresaliente aportación a la naciente ciencia con la distinción entre el "genotipo" (expresión de la constitución genética del organismo) y el "fenotipo" (características de un organismo que resultan de la interacción de su genotipo con el ambiente).
Bibliografía:http://cmcbemartineznderqui.jimdo.com/un-poco-de-historia/ -
Alfred Henry Sturtevant (1891-1970), elaboró el primer mapa genético de un organismo: la mosca del vinagre. Trabajo junto con Thomas Hunt Morgan (1866-1948). Bibliografía:http://bioinformatica.uab.es/genetica/curso/Historia.html
-
Alfred Henry Sturtevant (1891-1970), dedujo en 1913 que los genes deben colocarse de forma lineal sobre el cromosoma ocupando sitios específicos dentro de los mismos.
Bibliografía: http://es.calameo.com/read/00186856327614b8bc0f8 -
Robert Feulgen (1884 - 1955), describrió un método de hidrólisis con ácido clorhídrico llamado "tinción" basado en un colorante llamado "fucsina". Utilizando este método, descubrió la presencia de material cromosómico (o ADN) en el núcleo de todas las células eucarióticas, en forma de cromosomas. Bibliografía: http://cmcbemartineznderqui.jimdo.com/un-poco-de-historia/
-
Thomas Hunt Morgan (1866-1945), publicación del libro “El Mecanismo de la Herencia Mendeliana” que sentó definitivamente las bases de la herencia fenotípica. A partir de entonces las investigaciones se orientaron hacia el campo de las mutaciones, la química de la transmisión de los caracteres y la base molecular de la herencia. Bibliografía: http://es.calameo.com/read/00186856327614b8bc0f8
-
Calvin Bridges (1889-1938), demuestra definitivamente la teoría cromosómica de la herencia mediante la no disyunción del cromosoma X. Bibliografía: http://bioinformatica.uab.es/genetica/curso/Historia.html
-
Phoebus Levene (1869 – 1940), propuso un modelo para la conformación de los ácidos nucleicos: el tetranucleótido plano. Esta estructura respondía a los resultados sobre la composición de los ácidos nucleicos y la naturaleza de los enlaces covalentes que los componen.
Bibliografía: http://cmcbemartineznderqui.jimdo.com/un-poco-de-historia/ -
Frederick Griffith (1879 - 1941), postuló la existencia de un factor de transformación como responsable del fenómeno observado en su experimento de bacteria Streptococcus peumoniae que producía neumonia y otra cepa que no la causaba. Bibliografía: http://biologiabiomolecular.blogspot.com/2013/07/historia-y-descubrimiento-del-adn.html
-
Barbara McClintock (1902-1992), es la primera en describir el proceso de interacción cruzada (o entrecruzamiento cromosómico) entre cromosomas homólogos durante la meiosis. Bibliografía: https://mujeryciencia.fundaciontelefonica.com/2009/11/04/barbara-mc-clintock-un-nobel-unico/
-
Barbara McClintock (1902-1992) y otro estudiante graduado, observaron cómo la recombinación de los cromosomas, y por tanto el fenotipo resultante, formaban la herencia de un nuevo rasgo. Demostró así la hipótesis, establecida tiempo atrás, de la existencia de una recombinación genética durante la meiosis. Bibliografía: https://mujeryciencia.fundaciontelefonica.com/2009/11/04/barbara-mc-clintock-un-nobel-unico/
-
Barbara McClintock (1902-1992), publicó el primer mapa genético del maíz, mostrando el orden de los tres genes en su cromosoma 9. Estos avances fueron la inspiración para importantes artículos. Bibliografía: https://mujeryciencia.fundaciontelefonica.com/2009/11/04/barbara-mc-clintock-un-nobel-unico/
-
William Astbury produjo el primer patron de difracción de rayos X que mostraba que el ADN tenía una estructura regular. Bibliografía: http://lianna-eladn.blogspot.com/2011/04/el-adn-lo-aislo-por-primera-vez-durante.html
-
Erwin Chargaff, encontró el patrón de los importes de las cuatro bases: adenina, citosina, guanina y timina. Así, se podría decir: A = T y G = C. Bibliografía: https://mujeryciencia.fundaciontelefonica.com/2009/11/04/barbara-mc-clintock-un-nobel-unico/
-
George Beadle (1903-1989) y Edward Lawrie Tatum (1909-1975), Establecen el concepto de un Gen-Enzima;los genes son elementos portadores de información que codifican enzimas. Bibliografía: http://es.calameo.com/read/00186856327614b8bc0f8
-
Conrad Waddington (1905-1975), acuñó el término epigenética. Él concebía el desarrollo y la herencia en términos de la “conversación” entre la información genética y el ambiente Bibliografía: http://epigenome.eu/es/1,22,601
-
Alexander Robertus Todd, estudiando las cuatro bases químicas del ADN (adenina, guanina, timina y citosina), encabezando el equipo que definió el modo en que las moléculas del azúcar y los grupos fosfato actúan con estas bases para formar nucleótidos (que son los componentes básicos del ADN). Bibliografía: http://cmcbemartineznderqui.jimdo.com/un-poco-de-historia/
-
Dr. Murray Barr y Bertram. Dr. Ewart, descubrieron la cromatina secual, conocida como el corpúsculo de barr. Bibliografía:http://es.calameo.com/read/00186856327614b8bc0f8
-
Rosalind Franklin y Maurice Wilkins, realizaron los primeros estudios físicos con el DNA mediante la técnica de difracción de rayos X y concluyeron que: Bibliografía: http://biologiabiomolecular.blogspot.com/2013/07/historia-y-descubrimiento-del-adn.html
-
Alfred Hershey y Martha Chase, realizaron una serie de experimentos destinados a confirmar que el ADN era la base del material genético. Bibliografía: http://cmcbemartineznderqui.jimdo.com/un-poco-de-historia/
-
James Watson y Francis Crick (1916- 2004), descubrieron la estructura molecular del DNA. http://www.batanga.com/curiosidades/2010/07/20/grandes-cientificos-watson-crick
-
Frederick Sanger, determinó la secuencia de los aminoácidos de la insulina. demostró que las proteínas tienen estructuras específicas. Bibliografía: http://cmcbemartineznderqui.jimdo.com/un-poco-de-historia/
-
Arthur Kornberg (1918 - 2007), logró sintetizar una forma artificial de ADN en el laboratorio, pero resultó biológicamente inactivo. Bibliografía: http://cmcbemartineznderqui.jimdo.com/un-poco-de-historia/
-
Matthew Meselson y Franklin Stahl, proponen la replicación de AND en forma semiconservativa. Bibliografía: http://es.calameo.com/read/00186856327614b8bc0f8
-
Marshall Warren Nirenberg, Oswald Avery, Francis Crick, James Watson y otros, realizaron un experimento sobre el funcionamiento biológico y químico del AND respecto de sus funcionalidades de transmisión de la información genética. Bibliografía:http://es.calameo.com/read/00186856327614b8bc0f8
-
Sidney Brenner, François Jacob y Meselson, descubren el ARN mensajero. Bibliografía:http://bioinformatica.uab.es/genetica/curso/Historia.html
-
Marshall Nirenberg y Har Gobind Khorana, terminan de desvelar el código genético. Bibliografía: http://bioinformatica.uab.es/genetica/curso/Historia.html
-
Arthur Kornberg y su equipo, logró sintetizar ADN en estado biológicamente activo. Bibliografía: http://cmcbemartineznderqui.jimdo.com/un-poco-de-historia/
-
Har Gobind Khorana (1922 - 2011), sintetizaron una copia totalmente artificial de un gen de levadura. Bibliografía: http://cmcbemartineznderqui.jimdo.com/un-poco-de-historia/ Bibliografía:
-
Francis Crick (1916- 2004), genera el Dogma central de la Genética Molecular. Bibliografía:http://es.calameo.com/read/00186856327614b8bc0f8
-
Frederick Sanger, desarrolló el método de secuenciación de ADN, conocido también como "Método de Sanger". Bibliografía: http://cmcbemartineznderqui.jimdo.com/un-poco-de-historia/
-
El científico británico Robert Edwards comenzó su investigación sobre la biología de la fertilización en la década de 1950 y alcanzo el éxito el 25 de julio de 1978, cuando nació la primera bebé probeta, Louise Brown. Bibliografía: http://www.agenciasinc.es/Multimedia/Ilustraciones/25-de-julio-de-1978-Nace-la-primera-bebe-probeta
-
Kary Banks Mullis, Inventó la técnica PCR (Polymerase Chain Reaction) para amplificar regiones de ADN. Bibliografía: http://www.chlaep.org.uy/descargas/curso_tb_mico_bacterias/reaccion_en_cadena_polimerasa.pdf
-
Craig Venter y su equipo lograr crear en el laboratorio una bacteria sintética con el mínimo de genes esenciales para la vida, menos aún que el organismo más simple hallado en la naturaleza. Bibliografía: http://www.elespanol.com/ciencia/20160324/111988873_0.html
-
James Kochenderfer, del Centro para la Investigación en Cáncer de los Institutos Nacionales de Salud de EE UU. Empleó la terapia génica a 12 pacientes con mieloma múltiple, los cuales después del tratamiento no recayeron. En este caso, modifica los linfocitos C extraídos del propio paciente para que genere un bloqueante (una proteína llamada CAR) de un receptor clave en la recidiva del mieloma, el BCMA. Bibliografía: http://elpais.com/elpais/2015/12/07/ciencia/1449478211_561909.html
Want to make a timeline like this?
Use Timetoast to turn dates, events, milestones, and phases into a clear visual timeline you can build and share. Timetoast is a timeline maker for work, school, research, and stories.